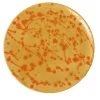
Carola fra i Trulli Piatto decorativo in ceramica arancione e caramello> Piatti Decorativi

Carola fra i Trulli Piatto decorativo in ceramica arancione e caramello> Piatti Decorativi
€109.47
SKU: SKUUC6A07fOAR Categories: Decorazioni, Oggetti Decorativi, Piatti Decorativi Tag: Carola Fra I Trulli Brand: Carola Fra I Trulli
Grande piatto decorativo da centrotavola in ceramica smaltata decorata a mano. Questo raffinato piatto da centrotavola è interamente realizzato a mano da abili artigiani italiani nel rispetto della storia, della natura e delle persone, reinterpretando la tradizionale tecnica del macchiato pugliese, emblema del marchio, come celebrazione della gioiosa spontaneità della natura mediterranea.
MaterialeceramicaDimensioni (cm)L 40 x P 40 x A 40Riferimento prodottoCAROBD-085Scheda pdf
Be the first to review “Carola fra i Trulli Piatto decorativo in ceramica arancione e caramello> Piatti Decorativi” Annulla risposta
Related products
Sale!
Decorazioni
€92.82
Decorazioni
€111.22
Decorazioni
€118.58
Sale!
Cachepot E Portavasi
€122.26
Cachepot E Portavasi
€127.78
€116.74
€56.94
Sale!
€124.19
Sale!
Bottiglie Decorative
Fornace Mian Vaso Narciso piccolo in ambra> Bottiglie Decorative
€122.35
Cachepot E Portavasi
Pot à Porter Vaso cilindrico in ceramica grigio maculato Portofino> Cachepot E Portavasi
€122.26
Login
Carola fra i Trulli Piatto decorativo in ceramica arancione e caramello> Piatti Decorativi
Questo sito utilizza i cookie per offrirti un'esperienza di navigazione migliore. Navigando su questo sito web, acconsenti al nostro utilizzo dei cookie.



































Reviews
There are no reviews yet.